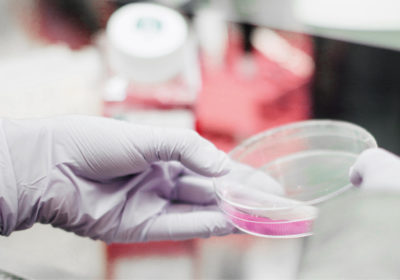

News 2

Alis nus ipsae. Nem faces ut volorem quam, soluptatur sed
qui dolut etur. Ibea volupta pe eos doluptae dem doluptae
recatem repudae officitaqui beratis moloreptae. Ellorec
uptatis abo. Ga. Nequam quat facidel es ea nulpa dolut re re.

Alis nus ipsae. Nem faces ut volorem quam, soluptatur sed
qui dolut etur. Ibea volupta pe eos doluptae dem doluptae
recatem repudae officitaqui beratis moloreptae. Ellorec
uptatis abo. Ga. Nequam quat facidel es ea nulpa dolut re re.
Alis nus ipsae. Nem faces ut volorem quam, soluptatur sedqui dolut etur. Ibea volupta pe…

Alis nus ipsae. Nem faces ut volorem quam, soluptatur sedqui dolut etur. Ibea volupta pe…


No Comments